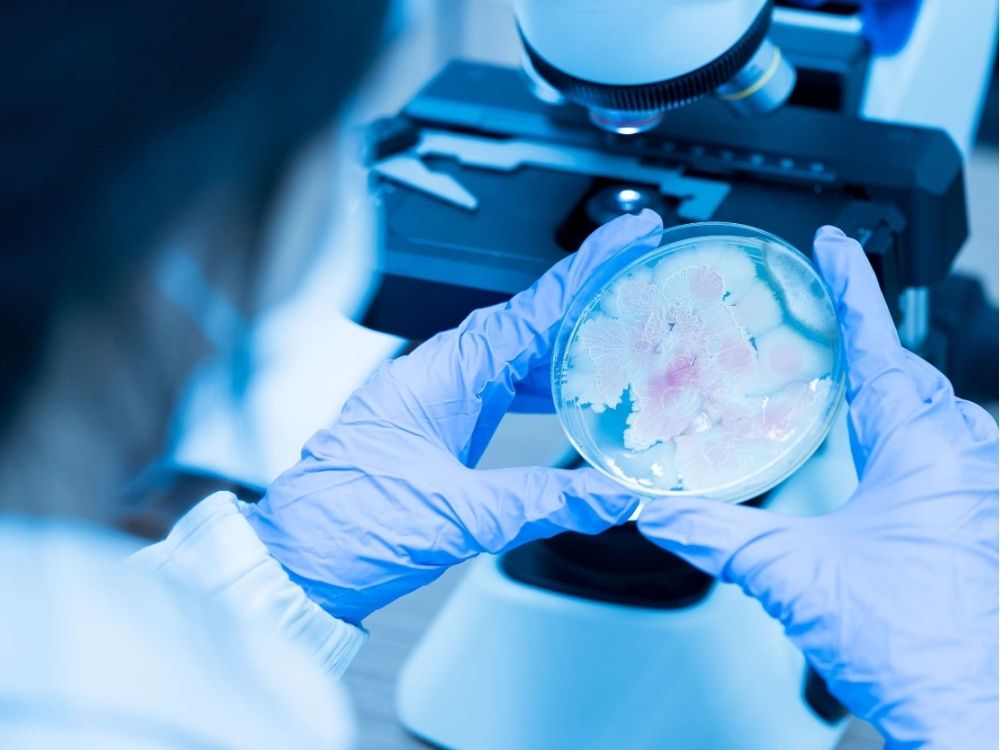

En la Universidad Católica del Maule se realizará el VII Simposio de Valoración y Conservación
de Recursos Microbianos, un encuentro clave para enfrentar los desafíos del futuro.
Los próximos 24 y 25 de septiembre, la Universidad Católica del Maule (UCM) se
convertirá en el epicentro de la biotecnología con la realización de la séptima edición del
Simposio de Valoración y Conservación de los Recursos Microbianos. Este evento, único en
Chile, busca consolidarse como un espacio vital para abordar grandes desafíos de la región y el
país, como el cambio climático, la demanda de alimentos y las energías renovables, a través del
potencial de la biotecnología.
Organizado en conjunto por el Instituto de Investigaciones Agropecuarias (INIA) Quilamapu, la
Escuela de Ingeniería en Biotecnología de la UCM, el Doctorado en Biotecnología Traslacional y
la Facultad de Ciencias Agrarias y Forestales de la UCM, el simposio reunirá a destacados
investigadores, científicos y estudiantes, tanto de Chile como del extranjero.
Esta edición se centrará en la biodiversidad de levaduras y microorganismos extremófilos, áreas
con gran potencial para aplicaciones industriales, agrícolas y medioambientales. Sin embargo, el
evento está abierto a recibir trabajos de todos los campos de la biotecnología, fomentando una
discusión amplia y multidisciplinaria.
Un aspecto destacado del simposio es su fuerte carácter internacional. Gracias a su formato
híbrido, que combina la participación presencial en el Auditorio F-100A del Campus san Miguel
de la UCM, con una transmisión en vivo por el canal de YouTube de la Facultad de Ciencias
Agrarias y Forestales, el evento ha logrado conectar a más de 100 personas de más de 11 países
de América Latina y España en ediciones anteriores, fortaleciendo una valiosa red de
colaboración científica.
Como actividad complementaria, este año se realizará el «II Torneo de Genética de la UCM», un
innovador juego de cartas de estrategia basado en la ingeniería genética, que añade un toque
lúdico a la jornada académica.
El simposio contará con la participación de cuatro expositores de talla mundial (keynote
speakers), quienes presentarán sus últimas investigaciones y hallazgos:
Dr. Pablo Villarreal (Universidad Mayor, Chile), experto en ecología microbiana.
Dr. Francisco A. Cubillos (Universidad de Santiago de Chile, Chile), reconocido por su
trabajo con levaduras nativas de la Patagonia.
Dra. Lorena Carro (Universidad de Salamanca, España), una investigadora de prestigio
internacional en taxonomía y biodiversidad microbiana.
Dra. Ángela Contreras Castro (Universidad Católica del Maule, Chile), especialista en el
uso de microorganismos para la industria alimentaria.
Además de estas ponencias principales, el programa incluye presentaciones orales y pósters de
trabajos de investigación seleccionados provenientes de países como Argentina, Ecuador,
Colombia, Perú, Paraguay y Chile, subrayando la relevancia del simposio en la comunidad
científica latinoamericana.